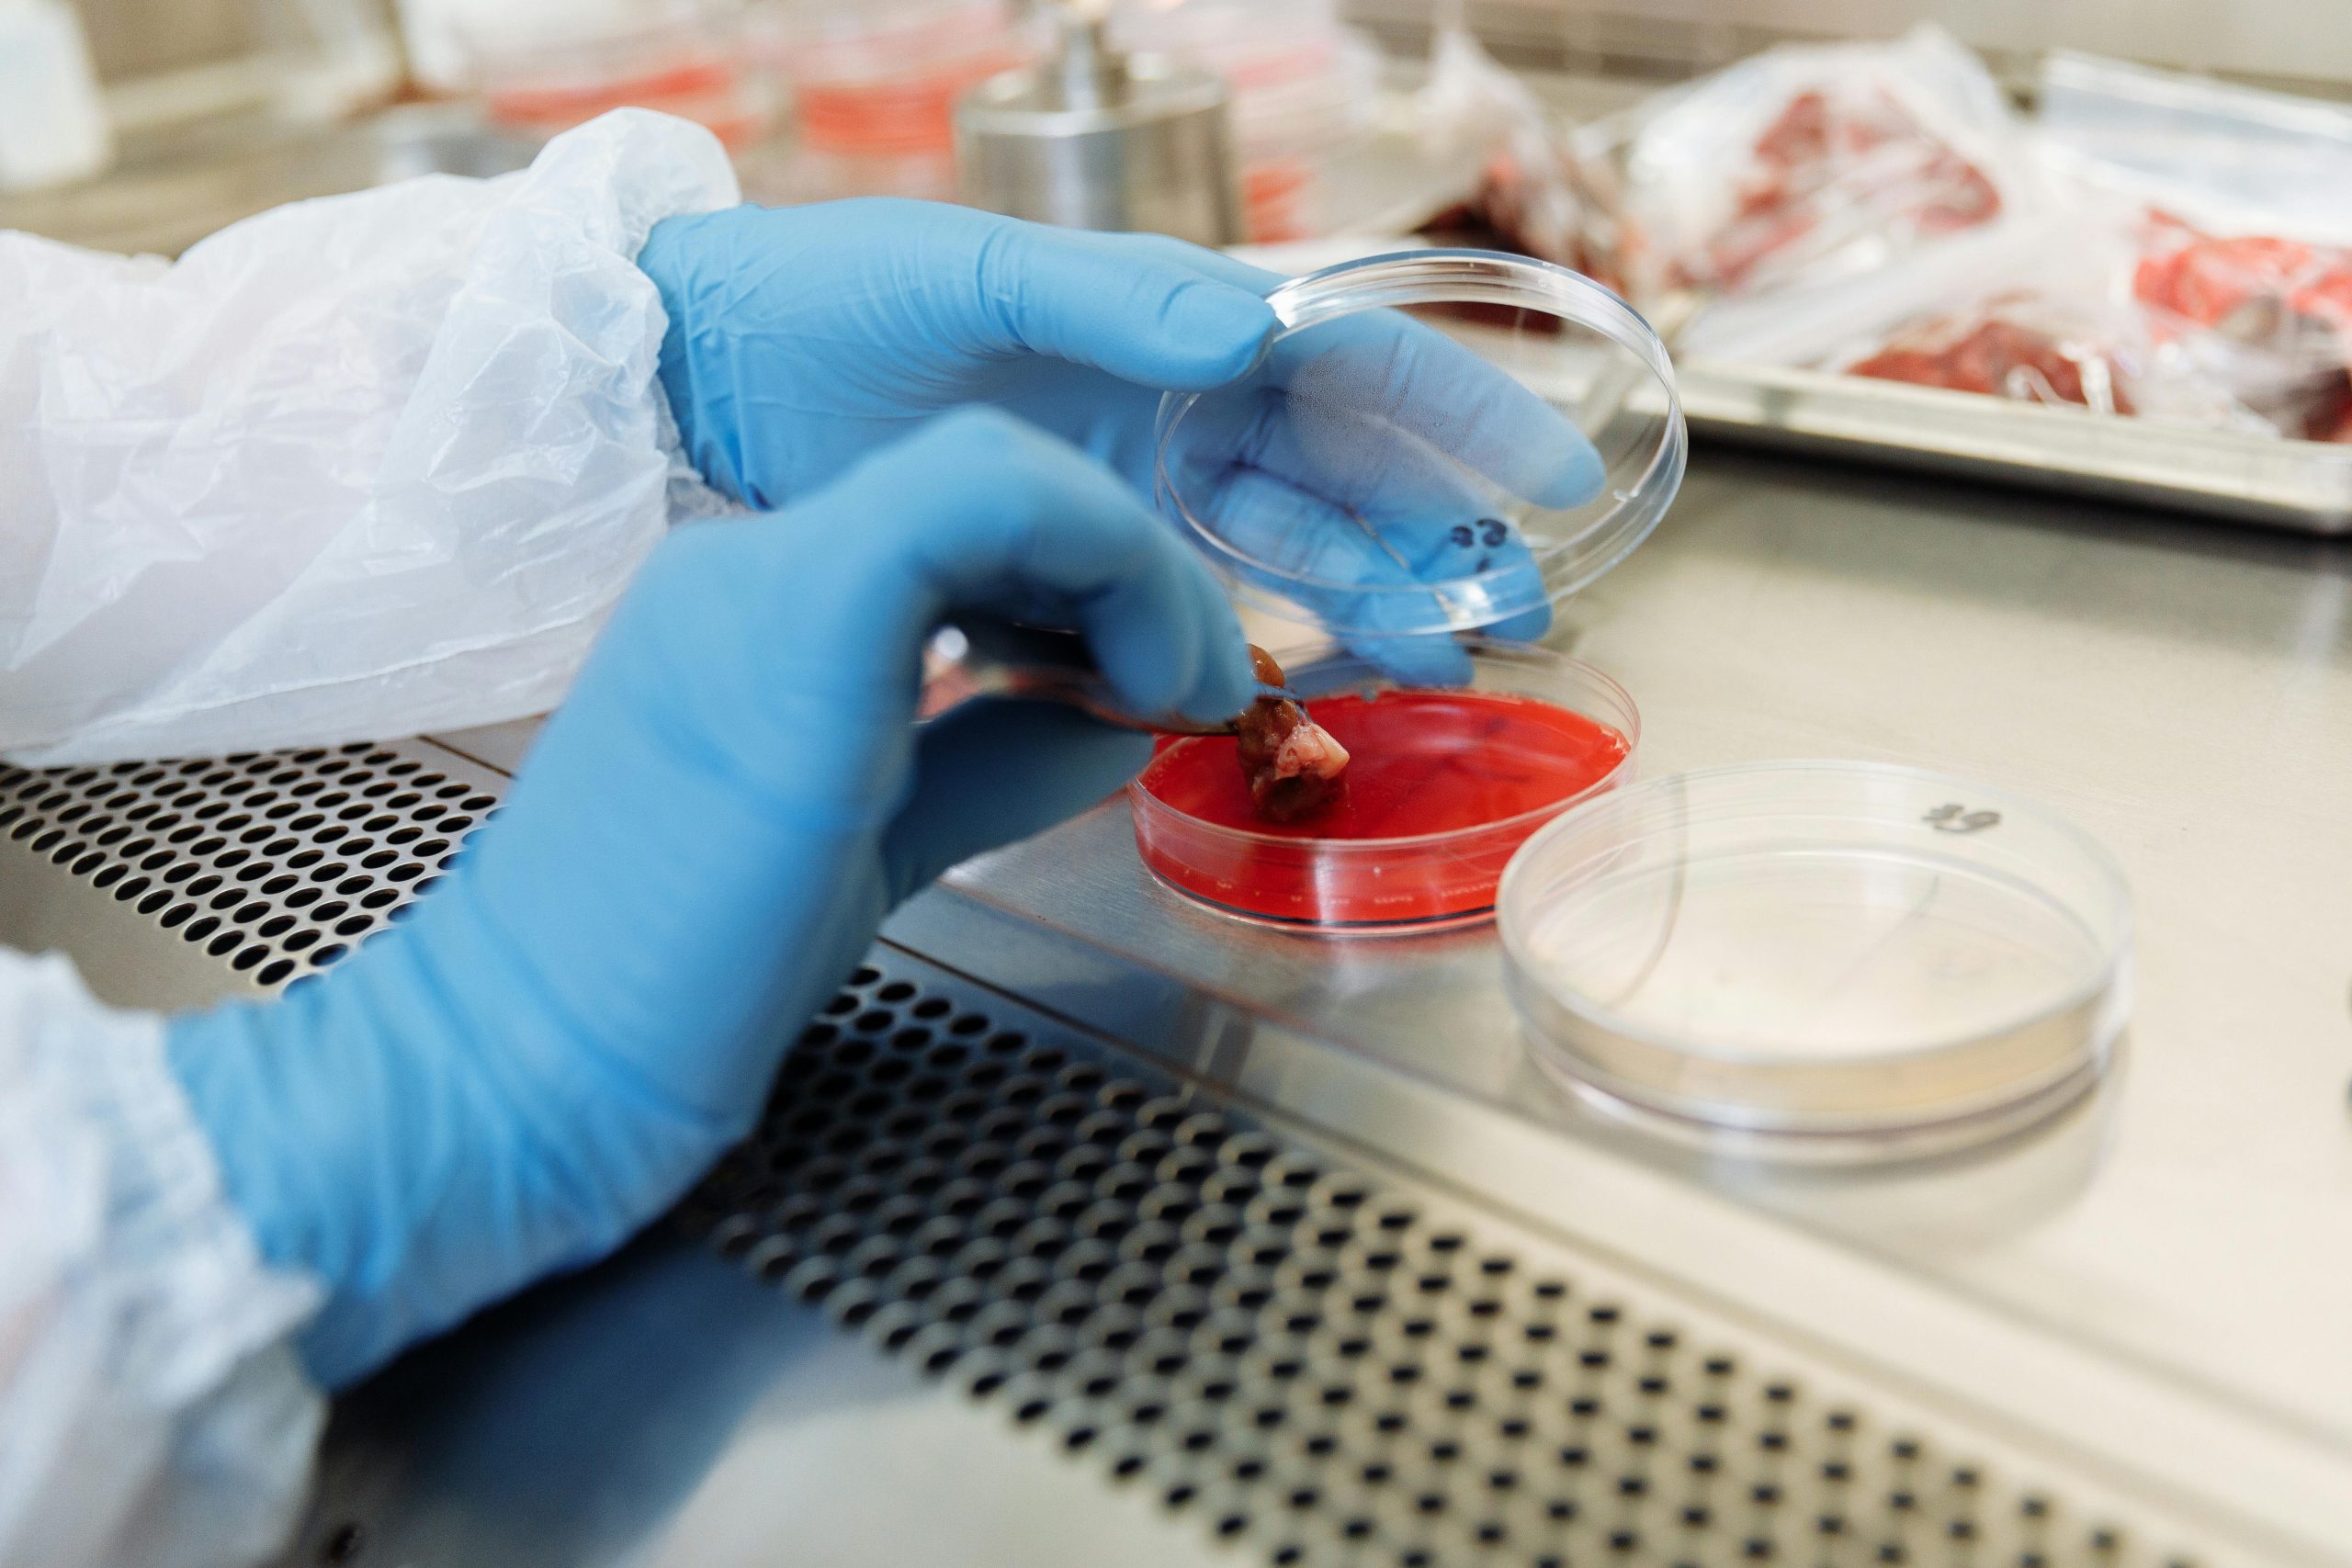
Close-up of gloved hands using petri dish and tweezers in a lab environment.

Trusted Mould Inspection &
Sampling Services in Ontario
Professional mould inspection, sampling, and assessment for homes, businesses, and property transactions.
Why Professional Mould Sampling Matters
Mould grows in damp or poorly ventilated spaces and can spread quickly once conditions are favourable. Certain types of mould can affect indoor air quality and trigger health symptoms when spores are inhaled or disturbed. That’s why Ontario building standards recommend proper identification and sampling of mould before renovations, property transfers, or when unexplained moisture issues arise.
Working with trained mould sampling specialists ensures:
- Compliance with Ontario indoor air quality guidelines
- Protection for occupants, employees, and visitors
- Accurate documentation for real estate and insurance needs
- Confidence before renovation or remediation begins
Our Mould Sampling Services
Visual Inspection & Moisture Assessment
Mould Air Quality Sampling
Surface & Bulk Sampling
Detailed Reporting & Interpretation
Who We Serve

We provide mould sampling services for a variety of clients, including:
- Homeowners – for health concerns or before renovations
- Real Estate Agents & Property Inspectors – to support sale/purchase decisions
- Commercial Property Owners – to ensure safe work environments
- Landlords & Tenants – for rental property investigations
- Facility & Building Managers – for proactive indoor air quality monitoring
- Insurance & Restoration Companies – for claims support and documentation
Why Work with Us
Experienced Professionals
Our team has extensive experience in environmental sampling and indoor air quality assessment, giving you reliable results you can trust.
Clear Communication
We provide fast turnaround times, clear explanations of findings, and practical advice on what comes next.
Independent & Unbiased
Our sampling and reporting are done independently — we focus on accurate data and recommendations, not remediation sales.
Request a Quote
Areas We Serve

We provide professional mould sampling and indoor air quality services across Ontario. If you’re unsure whether your area is included, contact us and we’ll be happy to help.
Serving Clients in:
Aylmer, Amherstburg, Blenheim, Chatham-Kent, Dresden, Essex, Glencoe, Kingsville, Leamington, London, Petrolia, Ridgetown, Rodney, Sarnia, Tilbury, Wallaceburg, West Lorne, Wheatley, Windsor and surrounding areas.
